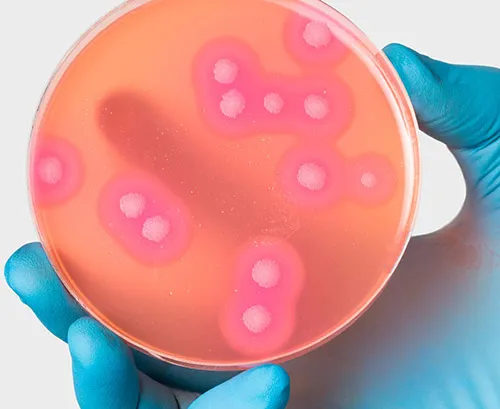

SolarVac 1201 -MB -T Vacuum Filtration System

Multivac 601 - MB - A Mufti-Branch Filtration System

Multivac 301 - MB -T Mufti-Branch Filtration System

Multivac 310-MS-T Multi-Branch Filtration System

SolarVac 601 - MB - T Vacuum Filtration System

Multivac 301 -MB-A Multi-Branch Filtration

Multivac 610- MS -A Multi-Branch Filtration System

Multivac 610- MS -A Multi-Branch Filtration System

solarvac 1201 - MB -A Vacuum Filtration System

Multivac 601 - MB -A Multi-Branch Filtration System

Multivac 310 - MS - A Multi-Branch Filtration System